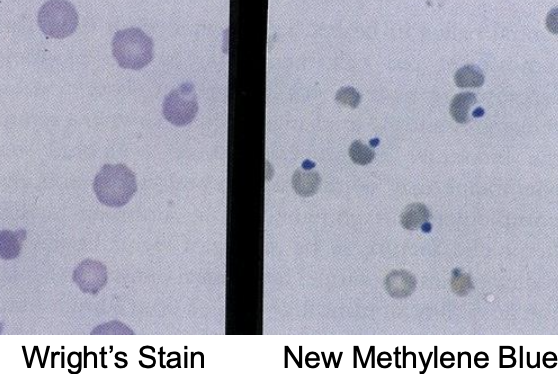
<p>can induce intra- AND extra-vascular hemolysis</p>
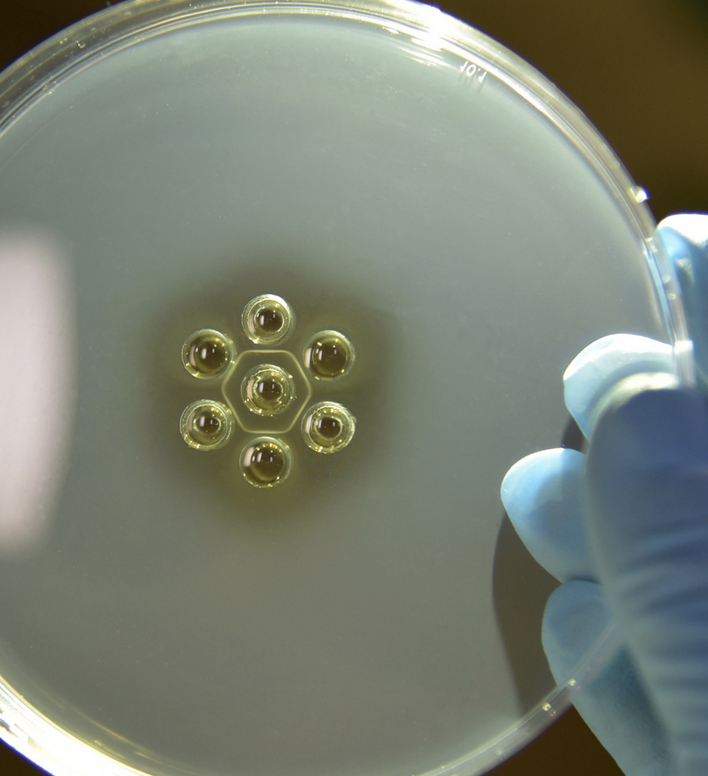
<p>1. serology (coggins test): AGID, ELISA</p><p>-seroconversion in 10-14 days post infection</p><p>2. rule out other causes of thrombocytopenia/anemia/vasculitis</p><p>-anaplasmosis, EVA, purpura, AHS</p>

3. large animal med- hemolymphatics #3 hemolytic anemia
1/57
There's no tags or description
Looks like no tags are added yet.
Name | Mastery | Learn | Test | Matching | Spaced | Call with Kai |
|---|
No analytics yet
Send a link to your students to track their progress
58 Terms
what is intravascular hemolysis?
RBCs lyse in the bloodstream
will see hemoglobinemia and subsequent hemoglobinuria

what is extravascular hemolysis?
antibodies bind to RBCs, which are then destroyed outside the bloodstream by phagocytes (macrophages) in spleen, liver, and bone marrow
will see hyperbilirubinemia

t or f: extravascular hemolysis is always present concurrently with intravascular hemolysis
true
what is equine piroplasmosis?
tick-borne disease caused by one (or both) species of hemoparasite:
1. babesia caballi
and/or
2. theileria equi (reportable- considered a FAD)

how is equine piroplasmosis transmitted?
1 of 2 ways:
1. multiple competent tick vectors (dermacentor, amblyomma, boophilus)
or
2. iatrogenic (sharing of dirty needles, blood doping)
what are the clinical signs of equine piroplasmosis?
-quiet to dull
-anorexia
-low grade fever
-icteric
-peripheral edema
-intravascular hemolysis (hemoglobinemia/-uria)
-peracute, acute, subacute, and chronic syndromes
-asymptomatic carrier states are common

which hemoparasite of equine piroplasmosis causes a more mild disease than the other?
b. caballi
how is equine piroplasmosis diagnosed?
-visualization of parasites in RBCs in early stages of dz during parasitemia
-PCR
-serology--> cELISA (seroconversion occurs about 14 days post-inoculation)

how is equine piroplasmosis treated?
with imidocarb:
-b. caballi: 2.2mg/kg IM daily for 2 days (easier to clear)
-t. equi: 4mg/kg IM q72hrs for 4 tx's (harder to clear- and toxicity may occur at higher doses of imidocarb)

what is the prognosis of equine piroplasmosis?
good prognosis with early treatment
how is equine piroplasmosis prevented?
quarantine
testing and environmental control of ticks is important to minimize spread from carriers and animals imported from endemic areas
what can bovids get similar to equine piroplasmosis?
bovine babeiosis (B. bigemina, B. bovis), important but NOT in USA

which animals are affected by leptospirosis-induced acute hemolytic syndrome?
calves and lambs
what 2 serovars of lepto. interrogans are associated with leptospirosis-induced acute hemolytic syndrome?
pomona and icterohaemorrhagicae

what are the clinical signs of leptospirosis-induced acute hemolytic syndrome?
-fever, petechiae, lethargy, icterus
-variable anemia, leukocytosis, increased fibrinogen
-other systemic manifestations: renal, ocular, reproductive
how is leptospirosis-induced acute hemolytic syndrome diagnosed?
ID organisms in urine with dark-field microscopy
PCR
serum antibody titer
how do heinz body anemias occur?
result from oxidation of sulfhydryl groups on hemoglobin--> structure distortion leads to formation of heinz bodies
more significant oxidant induced injury can result in methemoglobinemia

can heinz body anemia induce intra- or extra-vascular hemolysis?
can induce intra- AND extra-vascular hemolysis
what is the etiology of heinz body anemia?
-phenothiazine tranqs
-toxic plants (red maple, brassica spp. allium spp.)
-selenium deficiency predisposes (due to decreased glutathione peroxidase activity)

what is the treatment for heinz body anemia?
-remove toxic source
-activated charcoal
-methylene blue (reduces metHb, NOT for use in horses)
-antioxidants (vitamin C)
-supportive care (IV fluids, blood transfusion if significant lysis)

which ruminants are most sensitive to copper toxicosis?
sheep

what are causes of primary copper toxicity?
1. excessive ingestion
-inappropriate grain mixes
-Cu:Mb ratio over 6:1
2. sheep have a narrow therapeutic window
-require 4-6ppm versus toxicity at 10-20ppm

what are causes of secondary copper toxicity?
1. phytogeneous exposure: subterranean clover (trifolium) causes a mineral imbalance and excessive copper retention
2. hepatogeneous exposure: pyrrolizidine alkaloid-containing plants--> cause liver damage--> decreased liver capacity to store and process copper

how is copper toxicity diagnosed?
-history and clinical signs
-high copper concentration in blood and liver
-in acute hemolytic phase: severe non-regen. anemia
-in pre-hemolytic phase of chronic toxicosis: elevated liver enzymes, high copper conc. in liver biopsy
with chronic copper toxicity, stressors can induce a hemolytic crisis

how is copper toxicity prevented?
-measure copper levels in liver biopsy if toxicity suspected
-identify and remove sources of excess copper
-ensure adequate dietary Mb and other cofactors (excess Mb can induce Cu deficiency)

what is the pathogenesis of water intoxication of calves?
young calves with sudden free access to drinking water
rapid ingestion of large amounts of water--> marked tonicity change of body fluids--> osmotic lysis of RBCs

what clinical syndromes are seen with water intoxication of calves?
-neurologic signs
-intravascular hemolysis (hemoglobinemia/-uria)
-hyponatremia and hypochloremia
-serum hypo-osmolarity

how is water intoxication in calves treated?
restriction of free water intake
restoration of blood osmolarity (saline administration IV)

which animals are affected by post-parturient hemoglobinuria?
post-parturient dairy cattle within a month of calving
incidence is sporadic

what is post-parturient hemoglobinuria? what clinical signs are seen?
syndrome of intravascular hemolysis:
-marked anemia
-hemoglobinuria
-icterus
-depression
-marked decrease in milk production
-inappetance

what is the proposed pathogenesis of post-parturient hemoglobinuria?
severe hypophosphatemia negatively affects RBC energy metabolism and cell viability
-increased susceptibility of RBC lysis (RBCs more fragile)
-associated with copper and selenium deficiency in 1 herd

when is icterus seen in cases of extravascular hemolysis?
icterus seen if bilirubin production exceeds the livers clearance rate

what is primary IMHA?
aka auto-immune hemolytic anemia:
-patients RBCs are recognized as foreign by the immune system, leading to antibody generation

what is secondary IMHA?
IMHA caused by viral, bacterial, parasitic, and/or neoplastic causes
causes damage to RBC surface, and misdirected Ab cross-reactivity occurs
what are the clinical signs of IMHA?
-signs associated with moderate to severe anemia (increased HR and RR, pallor, lethargy)
-intermittent fever
-signs associated with purpura, lymphoma, chronic bacterial infections
-signs of dz being treated with procaine penicillin or TMS
how is IMHA diagnosed with CBC and chemistry?
CBC: regenerative anemia, +/- spontaneous agglutination
chem: unconjugated (indirect) hyperbilirubinemia
besides CBC and chem panels, how else can IMHA be diagnosed?
-flow cytometry for RBC surface antibodies (good sensitivity)
-saline agglutination test (false negative common)
-direct coomb's test (positive=Ab present on RBC membrane; false negatives common)

how is IMHA treated?
-address and remove cause (medications, underlying dz)
-immunosuppression (steroids- decreases antibody production and decreases RBC removal)
-blood transfusion if needed

what is the causative agent of equine infectious anemia (EIA)?
equine infectious anemia virus (lentivirus)

how is EIA transmitted?
transmitted via blood of infected horses:
-biting insects
-iatrogenic (needle sharing)
-in utero (vertical transmission)
what is the incubation period of EIA?
1-4 weeks
what are the 3 clinical stages of EIA?
1. acute
2. chronic
3. inapparent (long-term infection)

what is the acute stage of EIA? clinical signs?
the most severe stage of EIA:
-high fever and thrombocytopenia
-lethargy
-inappetence
-petechiae or ecchymoses

what is the chronic stage of EIA? clinical signs?
progressively less intense periods of clinical signs seen:
-anemia
-depression
-weakness
-peripheral edema
-weight loss

what is the inapparent stage of EIA?
long-term infection, no clinical signs seen
but, these animals are reservoirs and will shed the virus

what is anemia in EIA due to?
anemia is from intra and extravascular hemolysis and reduced bone marrow activity
how is EIA diagnosed?
1. serology (coggins test): AGID, ELISA
-seroconversion in 10-14 days post infection
2. rule out other causes of thrombocytopenia/anemia/vasculitis
-anaplasmosis, EVA, purpura, AHS
what is the treatment for EIA?
none
confirmed cases must be either euthanized or marked as carriers and permanently quarantined
what is the most prevalent tick-borne disease of cattle globally?
anaplasmosis

what is the causative agent of anaplasmosis in cattle and sheep/goats?
cattle: anaplasma marginale
sheep/goats: anaplasma ovis

how is anaplasmosis transmitted in ruminants?
-biggest source of infection is chronically infected animals:
-transmission also via ticks and iatrogenically (sharing needles)
incubation period is 10-30 days

does anaplasmosis cause intra- or extra-vascular hemolysis?
extravascular hemolysis
what are the clinical signs in calves of anaplasmosis?
minimal/asymptomatic
what are the clinical signs of anaplasmosis in cattle over 2 years of age?
fever
increased HR and RR
anorexia
lethargy
decreased milk production
pale/icteric mm
severe anemia
cerebral hypoxia in some cases
ie older cattle have much more severe dz than calves
what occurs if cattle survive the acute phase of anaplasmosis?
if they survive the acute phase, they will remain persistently infected reservoirs and be asymptomatic for life
how is anaplasmosis in ruminants diagnosed?
1. blood smear (fresh): dot-like inclusion bodies in RBC margins
2. PCR
3. PCR to identify chronic carriers (cELISA)

how is anaplasmosis in ruminants treated?
-supportive care
-blood transfusion if needed
-oxytetracycline (does not completely clear, animal will remain persistently infected for life)
how is anaplasmosis in cattle prevented?
-tick control
-identification of carriers
-vaccination (not available in the US)
